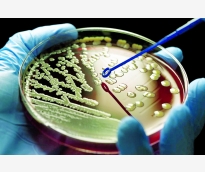
alsharq

أصدرت الخطوط الجوية القطرية تنبيهاً هاماً للمسافرين على متن الرحلتين QR914 وQR915 بين الدوحة وأوكلاند التأكد من حصولهم على تأشيرة أسترالية سارية المفعول،...
رئيس مجلس الإدارة : د. خالد بن ثاني آل ثاني

رئيس التحرير: جابر سالم الحرمي

مساحة إعلانية
كشف تقرير صادر عن وزارة الصحة العامة بعنوان «المضاد الحيوي الوطني 2023»، عن أنَّ العلاج الأولي المناسب بالمضادات الحيوية أظهر تحسنا في النتائج السريرية، بما في ذلك انخفاض الوفيات. ومع ذلك، يجب على مقدمي الرعاية الصحية في كثير من الأحيان اختيار نظام المضادات الحيوية قبل توافر نتائج المزرعة، كما أظهرت الدراسات أن نظام المضادات الحيوية التجريبية غير الفعال يمكن أن يكون ضارا للمرضى بينما يمكن أن تؤدي المضادات الحيوية واسعة الطيف غير الضرورية إلى زيادة المقاومة. وتعد هذه الوثيقة هي أول مخطط وطني منشور لدولة قطر تم تطويره من قبل قسم علم الأحياء الدقيقة بمؤسسة حمد الطبية ويتكون من جزأين يمثل الأول بيانات مؤسسة حمد الطبية (المرضى الداخليين والخارجيين ووحدة العناية المركزة) والجزء الثاني يمثل بيانات مؤسسة الرعاية الصحية الأولية (العيادات الخارجية)، حيث تشكل مقاومة مضادات الميكروبات تهديدا عالميا، حيث من المتوقع أن تتجاوز الوفيات المنسوبة إلى العدوى المقاومة 10 ملايين سنويا بحلول عام 2050. - تعزيز العلاج التجريبي هذا وقد أشار التقرير إلى أنَّ إحدى الاستراتيجيات المعتمدة على نطاق واسع لتعزيز العلاج التجريبي المناسب بالمضادات الحيوية تتمثل في تنفيذ برامج الإشراف على مضادات الميكروبات، والهدف الأساسي لهذه البرامج هو وضع توصيات تجريبية للمضادات الحيوية للعدوى الشائعة لتحقيق ذلك، فإن أحد أهم الأدوات هو استخدام مضاد حيوي. - منصة تعاونية وبين التقرير التراكمي السنوي لمعدلات الحساسية لمضادات الميكروبات لمسببات الأمراض الميكروبية الشائعة في تركيبات مؤسسة حمد الطبية، أنَّ المضاد الحيوي هو قياس مناسب ومتاح على نطاق واسع لمسببات الأمراض والحساسية لدى المؤسسة، لضمان حصول المرضى على العلاج بالمضادات الحيوية التجريبية المناسبة بناء على موقع العدوى المشتبه به، وخصائص المريض، كما أنَّ هناك حاجة إلى أن تستند برامج الإشراف على مضادات الميكروبات إلى مخطط مضاد حيوي يوفر معلومات أكثر من المضاد الحيوي التقليدي، مع انعكاس لأنماط المقاومة المحلية بما في ذلك التوصيات الخاصة بالمتلازمات وتوزيع الكائن الحي لعدوى معينة، كما تقدم برامج الإشراف على مضادات الميكروبات منصة تعاونية جيدة مع علماء الأحياء الدقيقة السريرية لإنشاء مضادات حيوية أكثر تعقيدا لتحسين العلاج التجريبي بالمضادات الحيوية. مما يسلط الضوء على أهمية دمج المضاد الحيوي في أنظمة دعم القرار السريري بهدف توفير علاج فعال بالمضادات الحيوية التجريبية. - اتجاهات الكائنات الحية وتناول التقرير ملخصا لاتجاهات الكائنات الحية ذات الأهمية الصحية العمومية والوقاية من العدوى، مما يساعد المختصين في فهم وبائيات الكائنات الحية المعزولة من العينات السريرية الواردة من المنشأة، سواء كانت مسؤولة عن العدوى المرتبطة بالرعاية الصحية (HAI) أو العدوى المرتبطة بالمجتمع (CAI) ؛ ومن ثم لن يكون من الممكن التمايز بين العدوى المرتبطة بالرعاية الصحية أو العدوى المرتبطة بالمجتمع من هذه البيانات، حيث يمكن أن تختلف أنماط حساسية الكائنات الحية بشكل كبير بسبب مصدر الكائن الحي أو عدد المرضى أو عمر المريض أو التشخيص أو المرض السريري وضغط المضادات الحيوية الناتجة عن طرائق العلاج الشائعة. - مبادئ توجيهية وأشار التقرير إلى أن هذه الدراسة تتضمن المضاد الحيوي التراكمي المبين للكائنات الحية المدرجة البيانات المجمعة من جميع المرضى الداخليين والخارجيين ووحدات العناية المركزة، كما تم اختيار المضادات الحيوية المبلغ عنها بناء على المبادئ التوجيهية الصادرة عن معهد معايير المختبرات السريرية (CLSI) ووصفات مؤسسة حمد الطبية. على الرغم من تطوير معايير وإرشادات CLSI باستخدام أحدث المعلومات المتاحة في ذلك الوقت، يجب استخدام الإرشادات جنبا إلى جنب مع الحكم السريري والمعرفة الحالية ونتائج الاختبارات المعملية ذات الصلة سريريا لتوجيه علاج المريض.
362
| 06 يناير 2025

تشكِّل المضادات الحيوية تهديداً كبيراً على الصحة العامة عالمياً، لتأثيرها المباشر على الأشخاص في أي عمر وفي أي بلد في العالم، وفي هذا السياق أعدت وزارة الصحة العامة خطة مراقبة مقاومة مضادات الميكروبات (2030-2023)، وستوفر البيانات المتعلقة بالمراقبة الشاملة على أساس السكان لمقاومة مضادات الميكروبات فرصا لتعزيز المراقبة على أساس السكان إذا تم تكييفها مع سياق البلد، ويمكن استخدامها لتقديم المشورة لواضعي السياسات الصحية وتوجيه التخصيص الفعال للتمويل الموارد المالية لبرامج التخفيف من المقاومة. وأشارت خطة مراقبة مقاومة مضادات الميكروبات والتي حصلت الشرق على نسخة منها، إلى أنَّ دولة قطر شهدت ارتفاعاً كبيراً في استهلاك المضادات الحيوية، لذلك تعمل الدولة على تطوير حلول واستراتيجيات مبتكرة بالتعاون والتنسيق مع جميع المعنيين لزيادة الوعي ودعم الإجراءات الملموسة لمكافحة مقاومة مضادات الميكروبات وحماية الصحة العامة. وأوضحت خطة المراقبة أنَّ العدوى بالكائنات المقاومة للأدوية المتعددة تؤدي إلى أمراض خطيرة ودخول المستشفى لفترات طويلة، كما أنها تسهم في زيادة في تكاليف الرعاية الصحية، وارتفاع تكاليف أدوية الخط الثاني، وفشل العلاج، ويشير الدليل على سبيل المثال، في أوروبا، تشير التقديرات إلى وجود مقاومة مضادات الميكروبات ويصل إلى أكثر من تسعة مليارات يورو سنويا، وفقًا لمراكز السيطرة على الأمراض والوقاية منها (CDC)، كما تضيف مقاومة مضادات الميكروبات 20 مليار دولار إلى تكاليف الرعاية الصحية المباشرة في الولايات المتحدة، والتي لا تشمل خسائر تبلغ حوالي 35 مليار دولار من الإنتاجية سنوياً، كما وتعد مقاومة مضادات الميكروبات مثارا للقلق في العالم العربي. - إنشاء مراقبة وتهدف الخطة إلى إنشاء مراقبة مستقبلية مستمرة على المستوى الوطني في قطر وتقدير الاتجاهات في معدلات مقاومة مضادات الميكروبات، والكشف عن ظهور واحتمال انتشار هذه المنظمات، من أجل إعلام البرامج التي تصوغ مبادئ توجيهية للعلاج والوقاية من العدوى والوقاية من انتقال الميكروبات. - أهداف قابلة للقياس وسيتم تحقيق أهداف مراقبة مقاومة مضادات الميكروبات من خلال حزمة من الأهداف القابلة للقياس، توفير إطار لنهج تدريجي نحو تنفيذ المراقبة المستقبلية المستمرة القائمة على المختبرات، تعزيز الإبلاغ السنوي عن بيانات مقاومة مضادات الميكروبات على المستويين الوطني والعالمي، دور المكاتب الإقليمية والإقليمية والدولية للحد من الأمراض في دولة قطر والكشف عن الكائنات المقاومة الناشئة، تعزيز الاستخدام الآمن والفعال والعقلاني لمضادات الميكروبات في قطر. إنشاء نظام مراقبة لرصد الاتجاهات وفهم عبء مقاومة مضادات الميكروبات واستخدام البيانات في إنشائها. - مبادئ توجيهية وتضمنت الخطة حزمة من المبادئ التوجيهية لاستخدام مضادات الميكروبات، إبلاغ الإجراءات المطلوبة المحلية والوطنية وتقييم التقدم الذي أحرز في تنفيذ البرنامج الوطني لمقاومة مضادات الميكروبات، رفع مستوى الوعي حول مقاومة مضادات الميكروبات في دولة قطر بين المهنيين والمرضى والجمهور، تعزيز المعرفة من خلال المراقبة والبحث، وتركز خطة مراقبة مقاومة مضادات الميكروبات الحالية على مراقبة MDRO (الكائنات الحية المقاومة للأدوية المتعددة) في صحة الإنسان ويتم تفعيلها من قبل التنسيق الوطني، كما وسيتم دمج خطة مراقبة مقاومة مضادات الميكروبات في المستقبل مع مراقبة مقاومة مضادات الميكروبات في قطاعات الصحة الحيوانية والزراعة والبيئة وقطاع الأغذية للتوافق مع إطار الصحة الواحدة الذي اعتمدته دولة قطر. - خريطة التنفيذ التحقت دولة قطر بوحدة النظام العالمي لمكافحة مضادات الميكروبات التابع لمنظمة الصحة العالمية في عام 2020، استعدادا للمشاركة في النظام العالمي لمقاومة مضادات الميكروبات (GLASS-AMR)، تم تصميم وتنفيذ استراتيجية المراقبة وفقا لمنظمة الصحة العالمية، كما وتم تشكيل مجموعة عمل فنية وطنية لمراقبة مقاومة مضادات الميكروبات في عام 2019 لإنشاء ومراقبة التقدم المحرز في مكافحة مضادات الميكروبات، النظام الوطني لمراقبة مقاومة مضادات الميكروبات في دولة قطر وتنسيق تنفيذ خطط العمل مع المرافق من خلال اللجنة الوطنية لمكافحة مضادات الميكروبات تضم مجموعة العمل الفنية خبراء في علم الأحياء الدقيقة من مرافق الرعاية الصحية العامة والخاصة والوقاية من العدوى خبراء والصيادلة، وخبراء المختبرات من قطاعات الأغذية والصحة الحيوانية، والباحثين من المؤسسات الأكاديمية، هذا وقد تم تدريب أعضاء مختارين من مجموعة العمل الفنية على نطاق واسع من قبل خبراء المكتب الإقليمي لشرق المتوسط ومنظمة الصحة العالمية حول أهمية إعداد التقارير العالمية عن مقاومة مضادات الميكروبات، كما حصلوا على تدريب عملي على استخدام البرنامج الحاسوبي WHONET للترصد المحلي والوطني لمقاومة مضادات الميكروبات. وبعد مشاورات مكثفة مع أصحاب المصلحة ضمن مجموعة العمل الفنية المعنية بمراقبة مقاومة مضادات الميكروبات، اتخذت اللجنة الوطنية لمقاومة مضادات الميكروبات قرارا باختيار المختبر السريري بمؤسسة حمد الطبية وإنشاء مركز التنسيق الوطني لمقاومة مضادات الميكروبات (NCC) في وزارة الصحة العامة، وقد أنشأت لجنة التنسيق الوطنية فريق عمل لمراقبة مقاومة مضادات الميكروبات يضم علماء ميكروبيولوجيا من المختبر الوطني للبحوث، ونقاط الاتصال القطرية المعنية بالنظام العالمي لمقاومة مضادات الميكروبات (GLASS-AMR)، موظفي تكنولوجيا المعلومات من مؤسسة حمد الطبية، وأعضاء الفريق الوطني لمقاومة مضادات الميكروبات في وزارة الصحة العامة، ومديري البيانات الذين يقومون بالتحليل ومعالجة البيانات.
1344
| 06 سبتمبر 2024

قالت منظمة الصحة العالمية، اليوم الأربعاء، إن العالم يواجه أزمة صحية كبيرة حيث أصبح لدى البكتيريا القدرة على مقاومة المضادات الحيوية والتسبب في وفيات كان يمكن في السابق الحيلولة دون حدوثها. وأوضحت المنظمة في تقرير جديد أن هذا "التهديد الخطير لم يعد مجرد تنبؤ بالمستقبل بل إنه واقع بالفعل الآن في كل إقليم من أقاليم العالم، ويمكن أن يمس كل فرد في أي سن وفي أي بلد، فمقاومة المضادات الحيوية، والتي تحدث عندما تطرأ تغيرات على الجراثيم فتفقد المضادات الحيوية مفعولها لدى من يحتاجون إليها لعلاج العدوى، تشكل الآن تهديدا كبيرا للصحة العمومية". وأشار التقرير المعنون "مقاومة مضادات الميكروبات: تقرير عالمي عن الترصد"، إلى أن مقاومة مضادات الميكروبات تحدث مع العديد من العوامل المعدية المختلفة، ولكن التقرير يركز على مقاومة المضادات الحيوية لدى سبع جراثيم مختلفة تتسبب في أمراض شائعة وخطيرة مثل حالات عدوى مجرى الدم والإسهال والالتهاب الرئوي وحالات عدوى المسالك البولية والسيلان ويوثق مقاومة المضادات الحيوية، ولا سيما تلك التي تعد "الملاذ الأخير"، في جميع أقاليم العالم. وأشارت المنظمة في تقريرها إلى أنه "تم في كل من النمسا وأستراليا وكندا وفرنسا واليابان والنرويج وجنوب أفريقيا وسلوفينيا والسويد والمملكة المتحدة، تأكيد فشل العلاج الذي يشكل الملاذ الأخير من السيلان، أي الجيل الثالث من المضادات الحيوية من نوع لسيفالوسبورينات.
471
| 30 أبريل 2014
مساحة إعلانية
الأكثر مشاهدة

أكدت الدكتورة رانية محمد، مدير إدارة المدارس ورياض الأطفال الخاصة والقائم بمهام التراخيص الخاصة بوزارة التربية والتعليم والتعليم العالي، أن السياسة الجديدة لتنظيم...
24004
| 11 يونيو 2026

تنطلق بعد ساعات بطولة كأس العالم 2026، في نسخة تُعد الأكبر والأكثر استثنائية في تاريخ البطولة، فللمرة الأولى منذ انطلاق المونديال، تشهد المنافسات...
17448
| 10 يونيو 2026

نوهت وزارة الدفاع بإتاحة الفرصة للراغبين من أبناء القطريات ومواليد دولة قطر، للالتحاق بالخدمة الوطنية، بعدقرار وزير الدولة لشؤون الدفاع رقم (5) لسنة...
9776
| 09 يونيو 2026

حمل تطبيق الشرق
تابع الأخبار المحلية والعالمية من خلال تطبيقات الجوال المتاحة على متجر جوجل ومتجر آبل
الأكثر رواجاً
- 1 8 شروط لإعارة العامل لمنشأة أخرى في قطر للعمل بدوام كلي أو جزئي
يمكن للمنشأة التقدم بطلب إعارة لعامل من منشأته الحالية لمنشأة أخرى لفترة من الوقت دون الحاجة إلى تغيير جهة العمل، حيث يمكن للعامل...
7820
| 10 يونيو 2026
- 2 للمقيمين وفي 5 خطوات فقط.. كيف تحدث بيانات جواز السفر عبر مطراش؟
أوضحت وزارة الداخلية أن تطبيق مطراش يتيح للمقيمين خدمة تحديث بيانات جواز السفر في حال تجديده بسهولة، دون الحاجة إلى مراجعة مراكز الخدمات...
4604
| 10 يونيو 2026
- 3 حمد دلموك الوكيل المساعد لشؤون العمالة الوافدة بـ "العمل" في حوار شامل لـ الشرق: رقابة مشددة على مكاتب الاستقدام وإجراءات قانونية تصل لسحب تراخيص المخالفين
تطوير التشريعات والتحول الرقمي والرقابة ركائز استدامة سوق العمل مراجعة دورية للتشريعات المنظمة لسوق العمل لضمان حصول العامل على حقوقه الكاملة نقلة نوعية...
3794
| 11 يونيو 2026



